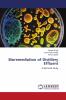
Bioremediation of Distillery Effluent

English
Paperback
₹3655
₹3847
4.99% OFF
(All inclusive*)
Delivery Options
Please enter pincode to check delivery time.
*COD & Shipping Charges may apply on certain items.
Review final details at checkout.
Looking to place a bulk order? SUBMIT DETAILS
About The Book
Description
Author
Waste management is a global issue with which the entire globe is currently grappling. The composition and characteristics of the pollutants in effluents are unknown which poses the greatest worry. Bioremediation is the method of utilizing the high and diversified metabolic activity of microorganisms to break down contaminants in industrial wastewater particularly distillery effluent. Their readily available nature and affordable price make them the preferred option. Bioremediation is the process of using bacteria with strong metabolic activity to break down contaminants in industrial effluents particularly distillery effluents. Microorganisms alone or in conjunction with other microorganisms create an environment conducive to not only the breakdown of toxicants but also the production of some useful by-products. This work focuses on the bioremediation of distillery effluent using bacterial strain. The book is of interest to students researchers teachers or any person interested in the topic.
Delivery Options
Please enter pincode to check delivery time.
*COD & Shipping Charges may apply on certain items.
Review final details at checkout.
Details
ISBN 13
9786206184430
Publication Date
-29-06-2023
Pages
-76
Weight
-111 grams
Dimensions
-150x220x4.5 mm